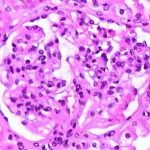

Revolutionizing Cancer Treatment: The Promise of Light-Activated Therapy
The emergence of light-activated immunotherapy has inspired excitement among researchers and clinicians alike. Recent collaborative work between bioengineers at The University of Texas at Dallas and experts at UT Southwestern Medical Center offers a hopeful outlook for patients facing advanced stomach cancer. In this opinion piece, we take a closer look at how this innovative approach could help reconfigure our understanding and treatment of metastatic cancer, while also examining the potential challenges and hidden complexities associated with such cutting-edge research.
Modern medicine has seen transformative shifts in therapeutic strategies over the past decades. The blending of technologies from fields as diverse as bioengineering and immunology is yielding methods that once would have seemed like science fiction. Harnessing light to activate tumor-targeting molecules, specifically engineered to bind to cancer cells, represents one of the more innovative directions in cancer therapy. By using far-red or near-infrared light to trigger these molecules, researchers aim to “prime” the immune system so it can attack stubborn cancer cells with precision.
Breaking Down the Science: Engineered Proteins and Light Activation
At the heart of this novel treatment strategy are lab-designed molecules known as betabodies. These engineered proteins are tailored to latch onto tumors while sparing healthy tissue. When activated by near-infrared light, these proteins create reactive molecules from captured oxygen—a process that not only kills cancer cells but also sparks the immune system into action. This dual approach, which combines targeted cellular destruction with immune system activation, could potentially offer a breakthrough in how we manage metastatic stomach cancer, particularly in patients where traditional treatments have been off-putting due to severe side effects.
Understanding the underlying mechanisms involves diving into several tricky parts of cellular biology:
- Binding Specificity: The engineered proteins are designed to attach solely to malignant cells, ensuring that healthy cells remain largely untouched. This precise targeting minimizes adverse effects commonly seen in conventional chemotherapy.
- Reactive Oxygen Species Generation: Once the proteins are activated by light, they convert oxygen into chemically reactive species. These, in turn, are lethal to cancer cells and stimulate a robust immune response.
- Immune System Engagement: The therapy acts as a double-edged sword by directly killing cancer cells and enhancing immune surveillance, potentially leading to longer-term remission.
This approach helps address some of the confusing bits and twists and turns often seen in conventional treatments: while chemotherapy and standard immunotherapy have provided periods of relief, many patients continue to endure severe side effects. By ensuring that the betabodies act only where needed, researchers are attempting both to improve effectiveness and reduce unintended harm.
Light Therapy Meets Immunotherapy: A New Frontier for Metastatic Stomach Cancer
The treatment of stomach cancer, especially when it has metastasized within the abdomen, is a formidable challenge. By the time many patients receive a diagnosis, the disease has often spread to a large area, making conventional treatment options both overwhelming and, at times, less effective. According to recent data, thousands of patients are diagnosed each year in the United States, and many do not respond well to existing therapies.
Here’s a breakdown of the current challenges in treating metastatic stomach cancer:
| Challenge | Description |
|---|---|
| Late Diagnosis | Patients are often diagnosed at an advanced stage, when the cancer has already spread widely. |
| Side Effects | Traditional treatments can damage healthy tissue, leading to a range of side effects that limit their usage. |
| Limited Survival | Even with advanced chemotherapy and immunotherapy, the average survival time post-diagnosis remains between 10 and 17 months. |
Researchers are hopeful that by combining a light-activated approach with these advanced engineered proteins, it will be possible to figure a path through even the most challenging pieces of this disease. The therapy is designed to be activated by a fiber-optic device that emits near-infrared light, a technique that is both innovative and less intrusive than many other surgical or radiation methods.
Engineered Proteins and Near-Infrared Light: Precision and Safety in Cancer Treatment
The idea of using engineered proteins, often referred to as betabodies, to specifically target tumor cells highlights an essential evolution in cancer treatment. In traditional cancer therapies, the tricky parts often arise from the inability to make a clear distinction between healthy and diseased cells. By focusing on proteins that can bind solely to cancer cells, this methodology not only reduces the damage to surrounding tissue but also helps reduce many nerve-racking side effects often associated with aggressive treatments.
In this approach, a two-step process is employed:
- Injection Phase: The engineered proteins are introduced into the patient’s abdomen. Their design ensures that they remain inactive until they encounter a light trigger, creating a targeted approach that minimizes collateral damage.
- Activation Phase: A fiber-optic device delivers near-infrared light directly to the tumor site. Upon activation, these proteins convert oxygen into reactive molecules, leading to the destruction of the cancer cells, and set off an inflammatory response that recruits immune cells to the site.
This fusion of light therapy and immunotherapy not only represents a novel treatment avenue but also challenges us to rethink our broader principles in managing difficult cancers. The promise of being able to treat patients with metastasized gastric cancer more effectively, while reducing harmful side effects, is an incredibly hopeful vision for the future of oncology.
Potential Across Various Tumor Types: Beyond Stomach Cancer
While the immediate focus of the research is on metastatic stomach cancer, the implications of this light-activated therapy stretch far beyond a single cancer type. The principles behind this new treatment could potentially be adapted for a variety of tumors that have proven hard to treat with conventional means. The application of near-infrared light combined with targeted engineered proteins offers a platform on which many different cancer therapies might be built.
Key potential benefits of adapting this method for other cancers include:
- Selective Targeting: The ability to restrict the action of these proteins to cancer cells could mitigate the harmful side effects typical of many cancer treatments.
- Enhanced Immune Response: Activating the immune system to respond to the presence of cancer cells could yield long-term benefits in preventing recurrence.
- Minimally Invasive Treatment: Using fiber-optic devices to deliver light minimizes the need for invasive surgical procedures, improving recovery times and overall patient comfort.
With further studies and clinical trials, we might see this approach move beyond stomach cancer to address problems that have, until now, been loaded with issues relating to off-target effects and limited therapeutic durability.
Bridging Basic Research and Clinical Application: Challenges and Considerations
As promising as the concept is, the road from laboratory discovery to bedside application is full of tricky bits and complex pieces that must be sorted out. Although early results in lab-based models and cancer spheroid cultures are encouraging, the therapy has not yet been fully tested in human subjects. This is a reminder that, while science continues to push boundaries, many steps remain before such treatments become a common option in clinical settings.
Some of the key challenges and considerations include:
- Clinical Trials: Before widespread use, this treatment must undergo rigorous testing in human clinical trials, which will assess both its safety and its efficacy in diverse patient populations.
- Dosage and Activation Timing: The precise amount of engineered protein and the appropriate light dosage required to maximize tumor destruction while avoiding harm to healthy tissues must be carefully determined.
- Device Innovation: The fiber-optic devices used to deliver near-infrared light need further refinement to ensure they can be safely and effectively used in a clinical environment.
- Patient Selection: Determining which patients will benefit most from this therapy based on tumor type, stage of disease, and overall health will be critical in optimizing outcomes.
Understanding these challenges reminds us of the twists and turns often seen in the progression from experimental treatments to established therapy standards. The field must navigate a series of nerve-racking regulatory, technical, and clinical hurdles before light-activated immunotherapy can become a widely available treatment option.
Collaborative Efforts: Strength in Partnerships Between Institutions
One of the most encouraging aspects of this research is the collaboration between institutions and experts from different fields. The synergy between bioengineers at UT Dallas and clinical researchers at UT Southwestern Medical Center exemplifies how combining unique skill sets can produce innovative solutions for challenging medical problems.
Partnerships of this kind help to:
- Share Expertise: Each institution contributes its particular strengths—be it in advanced engineering, clinical trial design, or the fine points of immunotherapy research.
- Accelerate Innovation: By pooling resources and knowledge, collaborative teams can often find creative solutions much faster than isolated groups working alone.
- Expand Impact: Partnerships open the door for a broader range of applications, potentially extending the benefits of a treatment to other types of cancer or even other diseases entirely.
This cooperative model stands as a testament to the progress that is possible when experts from diverse disciplines come together to tackle problems that are on edge in our current healthcare landscape. Such cross-disciplinary ties are not just beneficial—they are super important if we are to find more effective ways of dealing with the tangled issues of advanced cancers.
Understanding the Immune System’s Role in Light-Activated Therapy
The integration of engineered proteins and near-infrared light does more than just attack cancer cells directly—it also enlists the body’s own immune system to fight back. Through a process that is still being mapped out in its fine points, the therapy creates reactive oxygen species that are toxic to tumor cells, thereby releasing signals that attract immune cells to the area.
Here’s why this dual-action approach is considered so innovative:
- Direct Tumor Destruction: The reactive molecules generated by the activated proteins cause physical damage to the cancer cell membranes, leading to cell death.
- Immune System Engagement: The destruction of tumor cells releases antigens, which help the immune system identify and target remaining cancer cells more effectively.
- Potential for Long-Term Immunity: As the immune system begins to recognize tumor cells, there is hope that patients could develop a form of immunity against cancer recurrence.
This combination of therapies not only illustrates the delicate balance between targeted treatment and broad immune activation but also paves the way for new standards in cancer care. In a world where many current treatments seem intimidating due to their side effects and complex administration, the promise of a minimally invasive and precise treatment is a refreshing narrative worth watching closely.
Evaluating the Current Status of Research: Where Do We Stand?
While laboratory results have been promising, it is important not to overstate the progress made at this point. The research is still in the experimental phase and has yet to transition into routine clinical practice. Current efforts include:
- Laboratory Testing: Preliminary studies performed on cancer spheroid cultures have shown that the activated proteins effectively kill tumor cells while sparing normal cells.
- Animal Studies: Animal models are being used to ascertain the correct dosing and to evaluate any potential systemic side effects.
- Preparations for Clinical Trials: Researchers are in the process of designing human trials that will closely examine both safety and efficacy in patients diagnosed with advanced stomach cancer.
These steps are critical for confirming that the benefits seen in controlled lab settings can be safely replicated in the more variable conditions found in human patients. The medical community remains cautious yet hopeful that the therapy could one day offer patients a substantially improved prognosis.
Key Research Milestones: Understanding the Journey So Far
To help readers get a better grasp on the evolution of this groundbreaking therapy, consider the following timeline of key milestones in the research:
| Milestone | Details |
|---|---|
| Concept Development | Collaboration between UT Dallas and UT Southwestern Medical Center researchers to merge light therapy technology with engineered protein design. |
| Engineering Betabodies | Laboratory creation of tumor-targeting proteins that can be activated by near-infrared light. |
| Preclinical Studies | Initial experiments in cell cultures and animal models demonstrating effective tumor cell destruction and immune activation. |
| Funding Milestone | Receipt of a $250,000 High Impact/High Risk Research Award from the Cancer Prevention & Research Institute of Texas, underscoring the clinical potential of the approach. |
| Preparation for Clinical Trials | Design of future studies to evaluate the safety and efficacy of the treatment on patients with advanced stomach cancer. |
This timeline not only serves as a roadmap of where the research has been but also encapsulates the hope that the future might hold a more effective way to manage advanced cancers—a future where precision and safety go hand in hand.
Potential Impact on Patient Outcomes: A New Lease on Life
For patients facing a diagnosis of metastatic stomach cancer, the current treatment options can feel both intimidating and limited. With average survival times ranging between 10 to 17 months post-diagnosis, there is a clear, unmet need for novel therapies that could extend life expectancy and improve quality of life. The promise of light-activated therapy stems from its potential to address several of the tangled issues inherent in existing treatments.
Some key potential benefits for patients include:
- Reduced Side Effects: By selectively targeting only tumor cells, this therapy could reduce the nerve-racking side effects associated with conventional treatments.
- Enhanced Efficacy: The combined effect of directly destroying cancer cells and activating the immune system offers a two-pronged attack against a disease that is often full of problems.
- Improved Survival Rates: Optimistically, if clinical trials validate early findings, patients could enjoy extended survival times and a better quality of life.
Patients and their families, when faced with overwhelming treatment decisions, stand to benefit not just from a new treatment option, but from a treatment that works on multiple levels. This kind of innovation helps to steer through some of the most challenging parts of cancer care, offering a beacon of hope amidst an often daunting treatment landscape.
The Future of Cancer Therapy: Integration with Personalized Medicine
The rise of personalized medicine is reshaping the way we view treatment protocols for cancer and other complex diseases. The light-activated therapy discussed here is well-positioned to integrate with personalized treatment plans. Researchers are already exploring whether genomic profiling of tumors can inform the specific application of engineered proteins for each patient.
Key factors in this integration include:
- Patient-Specific Targeting: Tailoring the therapy to match the unique molecular signature of a patient’s tumor could potentially maximize treatment benefits.
- Adaptive Dosing: Real-time monitoring of a patient’s response may allow adjustments in the dosage and timing of both the engineered proteins and the light treatment.
- Reduced Toxicity: By combining personalized medicine with targeted therapy, the risk of systemic toxicity can be minimized, paving the way for safer treatment protocols.
As scientific understanding of the small distinctions between various tumor types grows, so too does the potential for refined and highly individualized treatment. This vision of the future is not far-fetched. It is built on the steady progress and continuous exploration of methods that combine technological innovation with a keen focus on patient safety and quality of life.
Addressing the Nitty-Gritty: Regulatory and Ethical Considerations
No discussion about a new therapeutic approach in modern medicine is complete without a look at the regulatory and ethical issues that invariably come into play. The state-of-the-art nature of light-activated therapy means that researchers must work through several layers of both ethical review and regulatory approval.
Some points of contention that need to be carefully managed include:
- Patient Consent: Ensuring that patients fully understand the experimental nature of the therapy, including potential risks and unpredictable outcomes.
- Clinical Trial Protocols: Designing trials that are robust enough to yield reliable data while still protecting patient welfare.
- Long-Term Effects: Monitoring patients over extended periods to identify any unforeseen complications that may arise from the treatment.
- Cost and Accessibility: Addressing the logistical issues of making such innovative treatments accessible to those who might benefit the most, regardless of socioeconomic status.
In summary, while the scientific breakthrough is exciting, the journey from the research bench to everyday clinical use is riddled with tension and layered with considerations that span the technical, ethical, and regulatory realms. Addressing these subtle details is as key to the success of the therapy as is perfecting its technical aspects.
Real-World Applications: How Light-Activated Therapy May Transform Oncology
The innovative potential of light-activated immunotherapy extends far beyond its immediate application in stomach cancer. If the therapy can be validated, it may well revolutionize our approach to treating other forms of cancer that have proven resistant to standard treatments. Consider the following points:
- Versatility Across Tumor Types: With some adaptation, this therapy could be used against tumors in other organs where conventional treatments are either too aggressive or insufficiently targeted.
- Minimally Invasive Procedures: The use of fiber-optic devices to administer near-infrared light reduces the need for invasive surgeries, potentially lowering complications and speeding up recovery time.
- Enhanced Immune System Collaboration: By tapping into the body’s natural defense mechanisms, this approach could lead to treatments that have lasting effects beyond merely eliminating visible tumors.
When viewed through the lens of a long-term healthcare strategy, light-activated immunotherapy represents a promising step forward—a shift toward methods that not only attack the immediate problem but also support the body’s inherent ability to keep cancer at bay over time.
Reflections on the Journey Ahead: Hopes, Challenges, and the Way Forward
As we reflect on the current progress of light-activated immunotherapy, it is clear that while the path forward is laden with several challenging parts and hidden complexities, the potential benefits for patients with advanced cancers cannot be overstated. The sophisticated design of engineered betabodies working in tandem with a targeted light activation system offers not just a new tool in the fight against cancer, but a paradigm shift in how we conceptualize treatment efficacy and safety.
The ongoing collaboration between UT Dallas and UT Southwestern Medical Center is a strong indicator that when innovative minds come together, even the most daunting and confusing bits of medical science can be reimagined into practical therapeutic solutions. It is a testament to the adaptability of modern medicine—a field built on continual progress and relentless inquiry.
For patients, caregivers, and medical professionals navigating an often intimidating healthcare system, such advancements provide a glimmer of hope. Even as current treatments remain limited for many patients with metastatic stomach cancer, the promise of extending life expectancy and enhancing the quality of life through more precise treatments is a conversation worth having and a journey worth pursuing.
Concluding Thoughts: A New Dawn in Cancer Therapy
In conclusion, the development of light-activated immunotherapy is a significant step toward redefining cancer treatment. The innovative use of engineered proteins that can be selectively activated by near-infrared light offers a sophisticated mechanism to target tumors with reduced side effects—a pressing concern in the realm of conventional therapies.
This approach not only reflects the ongoing evolution in the fight against cancer but also provides a crucial foundation for future personalized medicine strategies that consider every little twist and turn in a patient’s unique battle with the disease. While we are still in the early days of translating these laboratory successes into standard clinical practice, the collaborative spirit and technical ingenuity displayed by researchers underscore a promising future.
Moving forward, it will be essential for the medical community to remain both curious and cautious. Continued funding, rigorous clinical trials, and careful ethical oversight will all play key roles in ensuring that innovative therapies such as this one eventually reach the patients who need them most.
Ultimately, the light-activated approach to cancer treatment represents more than just a new therapy—it symbolizes a broader commitment to attacking complex and intimidating diseases with creativity, precision, and compassion. As research continues and clinical strategies are refined, the hope is that such breakthroughs will allow us to offer a renewed sense of hope and a longer, healthier life to those affected by some of the most challenging forms of cancer.
By taking a closer look at the science behind these cutting-edge techniques, and by carefully managing the many tangled issues along the way, researchers and clinicians alike are paving the road to a future where the fight against cancer is as much about empowering the immune system as it is about directly targeting disease. It is a future that is bright—almost as if illuminated by the very light used in these groundbreaking treatments.
Originally Post From https://news.utdallas.edu/health-medicine/light-activiated-cancer-therapies-2025/
Read more about this topic at
Team Creates Light-Activated Therapy To Target Hard-To …
Light-activated nanomaterials for tumor immunotherapy